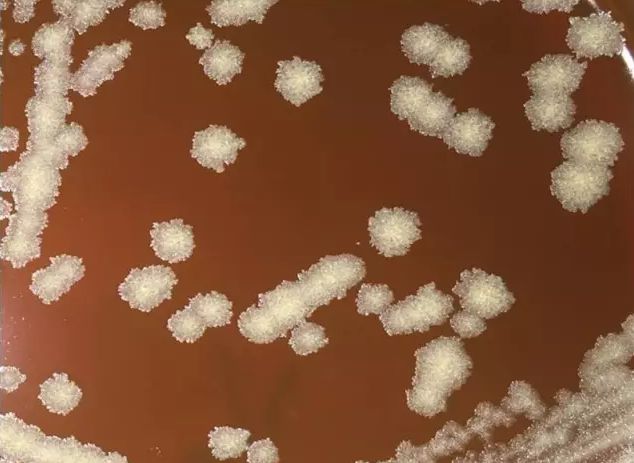

分歧桿菌菌落的三種形態(tài)
分歧桿菌菌落的三種形態(tài)
分枝桿菌是一種需氧的抗酸陽(yáng)性桿菌,廣泛存在于自然界和醫院相關(guān)環(huán)境中。目前,該菌屬包括150多個(gè)種,其中大多數菌種與人類(lèi)疾病密切相關(guān)。臨床上,分枝桿菌可引起結核、肺炎、麻風(fēng)病、導管相關(guān)性血流感染、手術(shù)和傷口感染等。此外,某些分枝桿菌還可以夠耐受酒精,在消毒的酒精中存活,并引起針炙后的分枝桿菌病。而在我們前面的微信稿件中,也介紹了一種可通過(guò)手術(shù)室變溫水箱和產(chǎn)生的氣溶膠引起心臟手術(shù)術(shù)后感染的奇美拉分枝桿菌??傊?,分枝桿菌是一種人類(lèi)疾病相關(guān)的重要病原菌,但是目前國內對于分枝桿菌的鑒定辦法卻不多。我們通過(guò)對近5年來(lái)收集和鑒定的40余株分枝桿菌,初步發(fā)現了分枝桿菌的3種菌落表型。
1、分枝桿菌的三種菌落形態(tài)
2011年以來(lái),我們采用基因測序技術(shù),先后在我院和幫助其他醫院完成40株分枝桿菌的鑒定,并通過(guò)其表型特征的觀(guān)察,發(fā)現了光滑型、粗糙型和中間型等三種不同的分枝桿菌菌落(見(jiàn)圖1-3)。



圖1、分枝桿菌的光滑型菌落

圖2、分枝桿菌的粗糙型菌落



圖3、分枝桿菌的中間型菌落
- 上一篇:智慧實(shí)驗室的發(fā)展現狀與趨勢 2022-08-01
- 下一篇:拉曼光譜在生物學(xué)研究中的應用 2022-08-01

